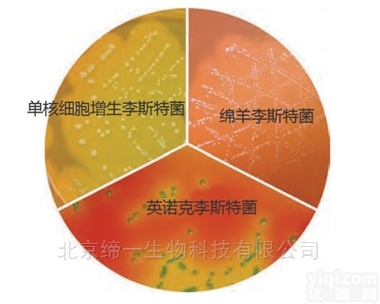
<em>M1924  单增李斯特氏菌显色培养基</em>

M1924 单增李斯特氏菌显色培养基
- 型号:M1924
- 供应商:上海威正翔禹生物科技有限公司
- 供应商报价:面议
- 标签:单增李斯特氏菌显色培养基,-1,上海威正翔禹生物科技有限公司
| 品牌 | 其他品牌 | 供货周期 | 一个月 |
|---|
单增李斯特氏菌显色培养基
(HiCromeTML.mono Rapid Differential Agar Base)
货号 | 产品 | 原装品名 | 规格 | 货期 | 储存 | 效期 |
M1924 | 单增李斯特氏菌显色培养基 | HiCromeTM | 500g(7.1L) | 4-6周 | 2-8°C | 详见包装品 |
FD214-5VL | 添加剂1 | L. mono Enrichment Supplement I | 5管(2.5L) | 4-6周 | -20°C | 详见包装品 |
FD181-5VL | 添加剂2 | HiCromeTM Listeria Selective Supplement | 5管(2.5L) | 4-6周 | 2-8°C | 详见包装品 |
单增李斯特氏菌显色培养基
应用
用于快速鉴定和鉴别单核细胞增生李斯特菌,并与其他李斯特菌物种相区分。
原理
主要基于“β-葡糖苷酶”、“鼠李糖发酵”和“PIPLC活性”(磷脂酰肌醇特异性磷脂酶C)。
李斯特氏菌特有的“β-葡糖苷酶”水解显色底物,菌落呈蓝色。其他菌无β-葡糖苷酶,菌落呈白色。
“鼠李糖发酵”和“PIPLC活性”区分李斯特内部菌种。单增李斯特氏菌鼠李糖阳性,菌落呈蓝绿色;同时PIPLC阳性,有不透明光环。绵羊李斯特菌(伊氏李斯特氏菌)有PIPLC活性而没有黄色背景(鼠李糖阴性)(2,3)。英诺克李斯特菌PIPLC阴性,没有不透明的光环。(4,5)。
培养基中的特殊蛋白胨、胰蛋白胨和大豆蛋白胨提供含氮物质、维生素B复合物和其他必需的营养成分。鼠李糖为发酵糖,酚红为指示剂。氯化钠维持渗透压平衡。氯化锂和添加剂1(FD181)YZ大多数革兰氏阳性菌、革兰氏阴性菌、酵母菌和霉菌生长。磷脂酶C水解添加剂2(FD214),通过在单增李斯特氏菌菌落周围产生不透明的光环,用以证明PIPLC活性的存在。
背景
单核细胞增生李斯特氏菌是一种革兰氏阳性食源性人类病原体,使孕妇严重感染并可能导致流产、死胎、新生儿李斯特氏菌病和脑膜炎或成人和青少年原发性菌血症。绵羊李斯特菌对人类的致病性不确定(1)。由于单核细胞增生李斯特氏菌和英诺克李斯特氏菌具有相似的生化特性,传统培养基(PALCAM)不能区分。
培养基组分
成份 | 克/升 |
特殊蛋白胨 | 23.000 |
胰蛋白胨 | 10.000 |
大豆蛋白胨 | 2.000 |
氯化钠 | 4.000 |
氯化锂 | 5.000 |
显色混合物 | 1.160 |
鼠李糖 | 10.000 |
酚红 | 0.120 |
琼脂 | 15.000 |
配置
35.14g干粉溶 470ml蒸馏水。加热使全溶。15磅(121℃)灭菌15分钟。冷却至45-50℃。无菌加入添加剂1,2(FD214和FD181)各1管。混匀并倒入无菌培养皿中。
警告:氯化锂是有害的。避免身体接触和吸入蒸气。一旦与皮肤接触,应用大量水冲洗。
质量控制
外观:淡黄~粉红粉末。
成胶性:牢固,与1.5%琼脂凝胶相当。
成品颜色和透明度:红色的不透明凝胶。
pH值:7.20-7.60
培养反应
加入添加剂后35-37℃孵育24-48小时。
有机体(ATCC) | 接种(CFU) | 生长 | 菌落颜色 | 鼠李糖发酵 | PIPLC活性 |
枯草芽胞杆菌(6633) | ≥103 | YZ | |||
白色念珠菌(10231) | ≥103 | YZ | |||
大肠杆菌(25922) | ≥103 | YZ | |||
英诺克李斯特菌(33090) | 50-100 | 旺盛 | 蓝绿色 | (+)黄色背景 | (-) |
绵羊李斯特菌(19119) | 50-100 | 旺盛 | 蓝绿色 | (-) | (+)菌落有不透明光环 |
单增李斯特菌(19118) | 50-100 | 旺盛 | 蓝绿色 | (+)黄色背景 | (+)菌落有不透明光环 |
绿脓杆菌(27853) | ≥103 | YZ |